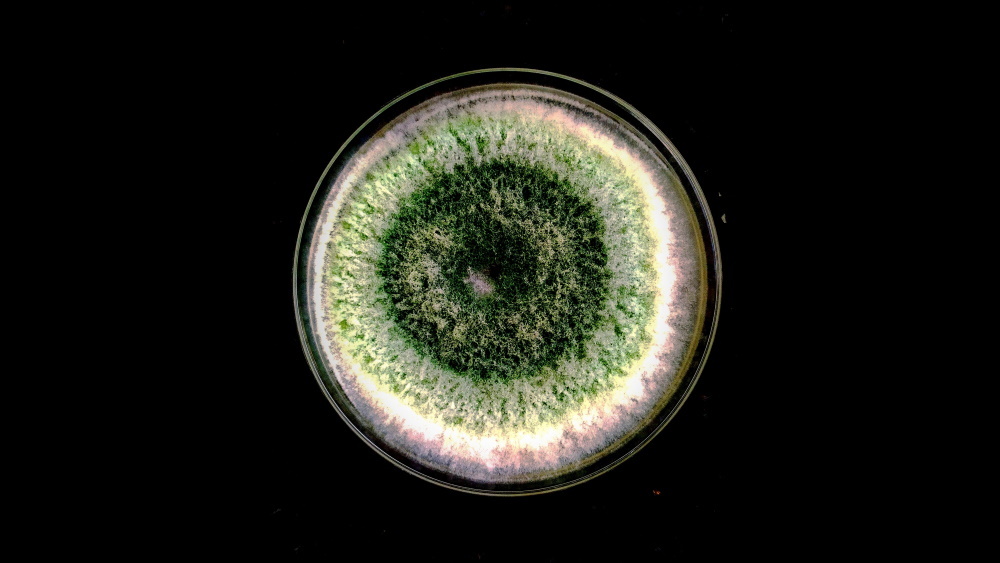

Недавнее исследование, опубликованное в журнале Biology Letters, показало, что монотонные звуки могут стимулировать активность грибка, который способствует росту растений. Открытие показывает, что музыка может помочь улучшения урожайности сельскохозяйственных культур и садов, сообщает Phys.org.
Австралийские ученые изучили, как звук влияет на скорость роста и спорообразование гриба Trichoderma harzianum. Этот гриб широко используется в органическом земледелии — он защищает растения от патогенов, улучшает питательные вещества в почве и стимулировать рост.
Исследователи поместили чашки Петри с образцами грибов в небольшие звукоизолированные камеры. Вместо музыки им воспроизводили «Tinnitus Flosser Masker» на частоте 8 кГц — аудиозапись белого шума, предназначенного для облегчения звона в ушах и баюкивания младенцев. Звук примерно похож на шум радио между каналами.
Грибам воспроизводили этот монотонный звук на громкости в 80 децибел на протяжении получаса ежедневно. Спустя пять дней оказалось, что грибки, подвергавшиеся звуковому воздействию, вырастают быстрее и производят больше спор, чем те, что находились в тишине.
Ученые предложили объяснение этого эффекта. Звуковая волна может оказаться преобразована в электрический заряд, стимулирующий грибы, по так называемому пьезоэлектрическому эффекту. Другая версия предполагает наличие механорецепторов на мембранах грибов, аналогичных тем, что имеются на человеческой коже и ответственны за осязание. Звуковые волны могут стимулировать эти механорецепторы в грибах, что, в свою очередь, инициирует каскад биохимических реакций, приводящих к активации или подавлению генов, ответственных за рост.